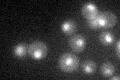
YGL035C
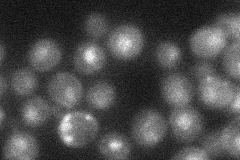
YGL035C
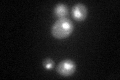
YGL035C
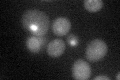
YGL035C

View description
Transcription factor involved in glucose repression; sequence specific DNA binding protein containing two Cys2His2 zinc finger motifs; regulated by the SNF1 kinase and the GLC7 phosphatase
Localization:
Intensity:
Fold change:
Significance:
-
C’ GFP library in SD
nucleus33.56 -
N' NOP1pr-GFP in SD

nucleus62.37 -
N' TEF2pr-mCherry in SD

nucleus50.8149 -
N' NATIVEpr-GFP in SD
nucleus30.5498 -
N' TEF2pr-VC and Cyto-VN in SD

cytosol,nucleus42.7493 -
C’ GFP library in SD+DTT
nucleus38.551.14No -
C’ GFP library in SD+H2O2

nucleus31.980.95No -
C’ GFP library in Starvation Media

nucleus33.520.99No -
C’ GFP library on the background of Pup2-DaMP
vacuole, cytosol -
C’ GFP library on the background of CCT mutant

nucleus39.65731.18138No
